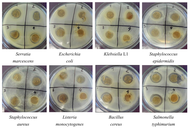

Editor's Picks
Open Access
Review
Agriculture, food security, and sustainability: a review
Agriculture is pivotal in securing global food security and sustainability, especially in pressing challenges such as climate change, population growth, and resource depletion. This review examines the interconnections between agriculture, food security, and sustainability, focusing on current challenges, innovations, and strategies to address these critical issues. The global demand for food is projected to increase substantially, necessitating agricultural systems that boost productivity and ensure environmental sustainability. However, conventional farming practices have exacerbated soil degradation, water scarcity, and greenhouse gas emissions, posing significant threats to long-term food security. This review aims to evaluate the role of sustainable agricultural practices in enhancing food security while mitigating environmental impacts. It also identifies existing gaps in farming systems and explores innovative solutions to promote resilient and sustainable food systems. A comprehensive review of peer-reviewed literature, policy documents, and global agricultural reports was conducted. The analysis focuses on key themes such as sustainable farming practices, the impacts of climate change on agriculture, advancements in agrotechnology, and the socio-economic dimensions of food security. Synthesized findings provide actionable insights into best practices and emerging trends. Sustainable agriculture offers a viable pathway to address the dual challenges of food security and environmental conservation. Precision farming, agroecology, and regenerative agriculture enhance productivity while preserving resources and reducing ecological footprints. Integrating advanced technologies, including artificial intelligence and genetic innovations, can optimize agricultural efficiency. However, global food security requires coordinated efforts among governments, the private sector, and local communities to implement equitable resource distribution and climate-resilient policies. Future research should prioritize scalable, region-specific solutions that align with sustainability principles to ensure a secure and resilient global food system.

Open Access
Review
From botany to bedside: a review of the health benefits of Lycium barbarum as a functional food
Native to East Asia and predominantly cultivated in regions such as the Ningxia Hui and Xinjiang Uyghur Autonomous Regions of China, Lycium barbarum (L. barbarum), commonly known as goji berry, has a long history in traditional medicine and is gaining recognition in contemporary health research. This review provides a comprehensive exploration of its botanical characteristics, pharmacokinetics, and safety, alongside a critical evaluation of human clinical studies investigating its therapeutic potential. Key health benefits include immune modulation, antioxidative effects, mental health support, ocular health preservation, and metabolic and cardiovascular regulation. Furthermore, its role in addressing age-related macular degeneration and chronic conditions such as cancer and metabolic syndrome is highlighted. The bioactivity of L. barbarum is attributed to its rich composition of polysaccharides, carotenoids, flavonoids, and other bioactive compounds, which exhibit anti-inflammatory, neuroprotective, and metabolic-regulating properties. This review also examines the safety profile of L. barbarum, considering its side effects, toxicity, potential contamination, and interactions with medications, emphasising the importance of balancing its health-promoting properties with cautious consumption. Despite promising findings, gaps in the evidence base, including the need for larger, long-term, and rigorously controlled trials, remain significant barriers to clinical translation. By integrating traditional medicinal knowledge with modern scientific insights, this review underscores L. barbarum’s potential as a functional food and therapeutic agent. Its unique pharmacological properties and broad applicability position it as a valuable tool for health promotion and disease prevention, while highlighting areas requiring further research to optimise its safe and effective use.

Open Access
Perspective
Future trends in Food Science and Foodomics: a perspective view by the Editorial Team of Exploration of Foods and Foodomics
In this perspective article, several internationally recognized experts, members of the editorial team of this journal, discuss a selection of current hot topics identified in Food Science and Foodomics. The topics are comprised of the main areas of Food Science and Foodomics, namely, food safety, food authenticity, food processing, and food bioactivity. Logically, several of the discussed topics involve more than one of the mentioned main areas. Regarding food safety, the topics discussed are the use of analytical nanotechnology, nanometrology, nano-chromatography; the determination of organic contaminants based on MS and NMR; the impact of microplastics and nanoplastics on food or the contamination of foods with plant toxins. Regarding food authenticity, the paper discusses the role of MS, NMR, biosensors and the new trends in foodomics for food authentication. In terms of food processing, the work shows interesting perspectives on novel processing technologies, the effect of food processing on the gut microbiota or in the interaction among secondary metabolites and macromolecules; the development of active packaging, and the potential effects of introducing recycled plastics in food packaging; the new green extraction and encapsulation strategies of bioactive compounds from food by-products; and the anti-biofilm capacity of natural compounds/extracts/vegetal oils and essential oils. Food bioactivity and the relation between food and health includes the bioavailability and bioaccessibility of bioactive compounds; new trends and challenges in the interaction of nutraceuticals with biological systems; how food matrix impacts the bioaccessibility of nutrients and bioactive compounds; or the study of biodiversity, food and human health through one-health concept. We anticipate elaborations on these hot topics will promote further studies in Food Science and Foodomics.

Articles
Latest
Most Viewed
Most Downloaded
Most Cited
Open Access
Review
Impact of food processing methods on the bioaccessibility and bioavailability of pearl millet minerals
Alhassan Wuni ... Felix Charles Mills-Robertson
Published: February 25, 2026 Explor Foods Foodomics. 2026;4:1010116

Open Access
Original Article
Nutritional composition and antioxidant potential of different seed parts of Nigerian Malabar chestnut (Pachira glabra Pasq.)
Adedamola Iyioluwa Akinyede, Daniel Sunkanmi Ajewole
Published: February 13, 2026 Explor Foods Foodomics. 2026;4:1010115

Open Access
Editorial
The food (r)evolution: innovations for food quality, safety, and sustainability
José Pinela, José Ignacio Alonso-Esteban
Published: February 12, 2026 Explor Foods Foodomics. 2026;4:1010114
This article belongs to the special issue The food (r)evolution towards food quality/security and human nutrition

Open Access
Original Article
Impact of mango kernel flour incorporation on the physicochemical and sensory properties of balady flatbread
Hafizuddin Ja’afar ... Eng Keng Seow
Published: February 09, 2026 Explor Foods Foodomics. 2026;4:1010113

Open Access
Original Article
Antagonistic activity of lactic acid bacteria strains and commercial bacterial starters
Rustem Khabibullin ... Sania Vildanova
Published: February 09, 2026 Explor Foods Foodomics. 2026;4:1010112
Open Access
Original Article
Biochemical interactions of dietary food contaminants with cytochrome P450 2E1: an in silico approach
Serkan SUGEÇTİ
Published: January 29, 2026 Explor Foods Foodomics. 2026;4:1010111
This article belongs to the special issue Food Contaminants: Analysis, Occurrence and Risk Assessment

Open Access
Review
AI-powered revolution in plant sciences: advancements, applications, and challenges for sustainable agriculture and food security
Deependra Kumar Gupta ... Ajay Kumar Singh
Published: August 06, 2024 Explor Foods Foodomics. 2024;2:443–459

Open Access
Perspective
Future trends in Food Science and Foodomics: a perspective view by the Editorial Team of Exploration of Foods and Foodomics
Elena Ibáñez ... Alejandro Cifuentes
Published: November 28, 2024 Explor Foods Foodomics. 2024;2:707–766

Open Access
Review
From botany to bedside: a review of the health benefits of Lycium barbarum as a functional food
Alois Berisha ... Tao Zhang
Published: January 25, 2025 Explor Foods Foodomics. 2025;3:101070
This article belongs to the special issue Natural Products in Health and Disease

Open Access
Review
Olive oil, fruit and leaves in diabetes mellitus type 2 treatment
Mario Nosić ... Ines Banjari
Published: October 29, 2023 Explor Foods Foodomics. 2023;1:192–205
This article belongs to the special issue Natural Products in Health and Disease

Open Access
Review
Efficacy of Mucuna pruriens (L.) DC. in treating diabetes, Parkinson’s disease, and erectile dysfunction—a review of clinical and preclinical trials
Ravindra Verma ... Prakash S. Bisen
Published: April 23, 2025 Explor Foods Foodomics. 2025;3:101083
This article belongs to the special issue Natural Products in Health and Disease

Open Access
Review
A concise review: edible mushroom and their medicinal significance
Jaya P. Ambhore ... Bhavana A. Shende
Published: May 17, 2024 Explor Foods Foodomics. 2024;2:183–194

Open Access
Review
Agriculture, food security, and sustainability: a review
Shahidul Islam
Published: April 14, 2025 Explor Foods Foodomics. 2025;3:101082

Open Access
Perspective
Future trends in Food Science and Foodomics: a perspective view by the Editorial Team of Exploration of Foods and Foodomics
Elena Ibáñez ... Alejandro Cifuentes
Published: November 28, 2024 Explor Foods Foodomics. 2024;2:707–766

Open Access
Review
AI-powered revolution in plant sciences: advancements, applications, and challenges for sustainable agriculture and food security
Deependra Kumar Gupta ... Ajay Kumar Singh
Published: August 06, 2024 Explor Foods Foodomics. 2024;2:443–459

Open Access
Review
Bioaccumulation of environmental pollutants and marine toxins in bivalve molluscs: a review
Clara Ochoa-Esteso ... María Jesús Lerma-García
Published: December 03, 2024 Explor Foods Foodomics. 2024;2:788–809
This article belongs to the special issue Food Contaminants: Analysis, Occurrence and Risk Assessment

Open Access
Review
Separation methods for food protein purification and analysis
Anushi Madushani Wijethunga, Chijioke Emenike
Published: July 30, 2024 Explor Foods Foodomics. 2024;2:391–407
This article belongs to the special issue Food Authenticity and Emerging Challenges of Novel Food

Open Access
Original Article
Effect of the production of dried fruit and fruit chips on chemical, sensory and bioactive properties
Bahar Kocabıyık, Derya Alkan
Published: March 10, 2025 Explor Foods Foodomics. 2025;3:101077

Open Access
Review
AI-powered revolution in plant sciences: advancements, applications, and challenges for sustainable agriculture and food security
Deependra Kumar Gupta ... Ajay Kumar Singh
Published: August 06, 2024 Explor Foods Foodomics. 2024;2:443–459

Open Access
Review
Recent advances in nano-related natural antioxidants, their extraction methods and applications in the food industry
Ayla Elmi Kashtiban ... Sayna Zahedinia
Published: April 19, 2024 Explor Foods Foodomics. 2024;2:125–154
This article belongs to the special issue The food (r)evolution towards food quality/security and human nutrition

Open Access
Review
Pickering emulsions in food and nutraceutical technology: from delivering hydrophobic compounds to cutting-edge food applications
Lucía Cassani, Andrea Gomez-Zavaglia
Published: July 30, 2024 Explor Foods Foodomics. 2024;2:408–442
This article belongs to the special issue Delivery of Hydrophobic Compounds in Food Systems

Open Access
Original Article
Development of soy whey fortified orange juice beverages: their physicochemical, rheological, antioxidant, and sensory properties
Hilal Ahmad Punoo ... Andleeb Muzaffar
Published: October 29, 2023 Explor Foods Foodomics. 2023;1:206–220

Open Access
Review
Encapsulation of hydrophobic compounds in yeast cells: methods, characterization, and applications
Deniz Günal-Köroğlu ... Esra Capanoglu
Published: June 20, 2024 Explor Foods Foodomics. 2024;2:252–274
This article belongs to the special issue Delivery of Hydrophobic Compounds in Food Systems

Open Access
Review
Agriculture, food security, and sustainability: a review
Shahidul Islam
Published: April 14, 2025 Explor Foods Foodomics. 2025;3:101082

Special Issues
Ongoing Special lssues
Completed Special lssues
Nutrition in Health and Disease
Guest Editor: Yutang Wang
Submission Deadline: August 30, 2026
Published Articles: 0

Food-Derived Bioactive Compounds: From Foodomics to Therapeutic Applications
Guest Editors: Antonio Di Stefano; Ivana Cacciatore
Submission Deadline: October 30, 2026
Published Articles: 0

Food and Foodomics in Oncology: From Molecular Mechanisms to Clinical Applications
Guest Editors: Marco Cintoni; Marta Palombaro
Submission Deadline: July 30, 2026
Published Articles: 0

Innovative Genetic Approaches to Food Authenticity and Safety Control
Guest Editors: Paula Martins-Lopes; Sara Barrias
Submission Deadline: July 30, 2026
Published Articles: 0

Omics Techniques for the Comprehensive Characterization of Food
Guest Editors: Luisa Mannina; Giacomo Di Matteo
Submission Deadline: July 30, 2026
Published Articles: 0

Oxidation and Antioxidant Strategies in Food Systems: From Mechanisms to Innovative Preservation Strategies
Guest Editors: Esra Capanoglu; Deniz Gunal-Koroglu
Submission Deadline: July 30, 2026
Published Articles: 0

Neuroprotective Potential of Natural Products from Foods
Guest Editors: Ana Sanches Silva; Muhammad Ajmal Shah
Submission Deadline: July 30, 2026
Published Articles: 0

Natural Bioactive Compounds in Functional Foods: From Foodomics Insights to Clinical Relevance
Guest Editor: Javad Sharifi Rad
Submission Deadline: July 30, 2026
Published Articles: 0

Organic and Inorganic Compounds in Foods and Plants from Latin America
Guest Editors: Bruno Lemos Batista; Bruno Alves Rocha; Camila Neves Lange
Submission Deadline: July 30, 2026
Published Articles: 2

Metrological Aspects in the Analysis of Nutrients, Functional Compounds, Additives and Contaminants in Food and Feed
Guest Editors: Maria Z. Tsimidou; Nives Ogrinc; Claudia Zoani
Submission Deadline: July 30, 2026
Published Articles: 13

Food Contaminants: Analysis, Occurrence and Risk Assessment
Guest Editors: Olga Pardo; Francesc A. Esteve-Turrillas
Submission Deadline: July 30, 2026
Published Articles: 5

Food Authenticity and Emerging Challenges of Novel Food
Guest Editors: Di Wu; Guoliang Li
Submission Deadline: July 30, 2026
Published Articles: 4

Natural Deep Eutectic Solvents in Food Chemistry and Advanced Food Materials
Guest Editors: Maria Fernanda Silva; Federico Gomez; Maria de los Angeles Fernandez
Submission Deadline: July 30, 2026
Published Articles: 1

New Generation Analytical Technologies in Food Analysis
Guest Editors: Bengi Uslu; Cem Erkmen
Submission Deadline: July 30, 2026
Published Articles: 3

Journal Information
Journal Indexing
Journal Metrics

















 Title: Unravelling the interplaybetween #Harmattan wind andbaroreflex functions: implicationon environmental health andcardiovascular #pathophys
Title: Unravelling the interplaybetween #Harmattan wind andbaroreflex functions: implicationon environmental health andcardiovascular #pathophys


